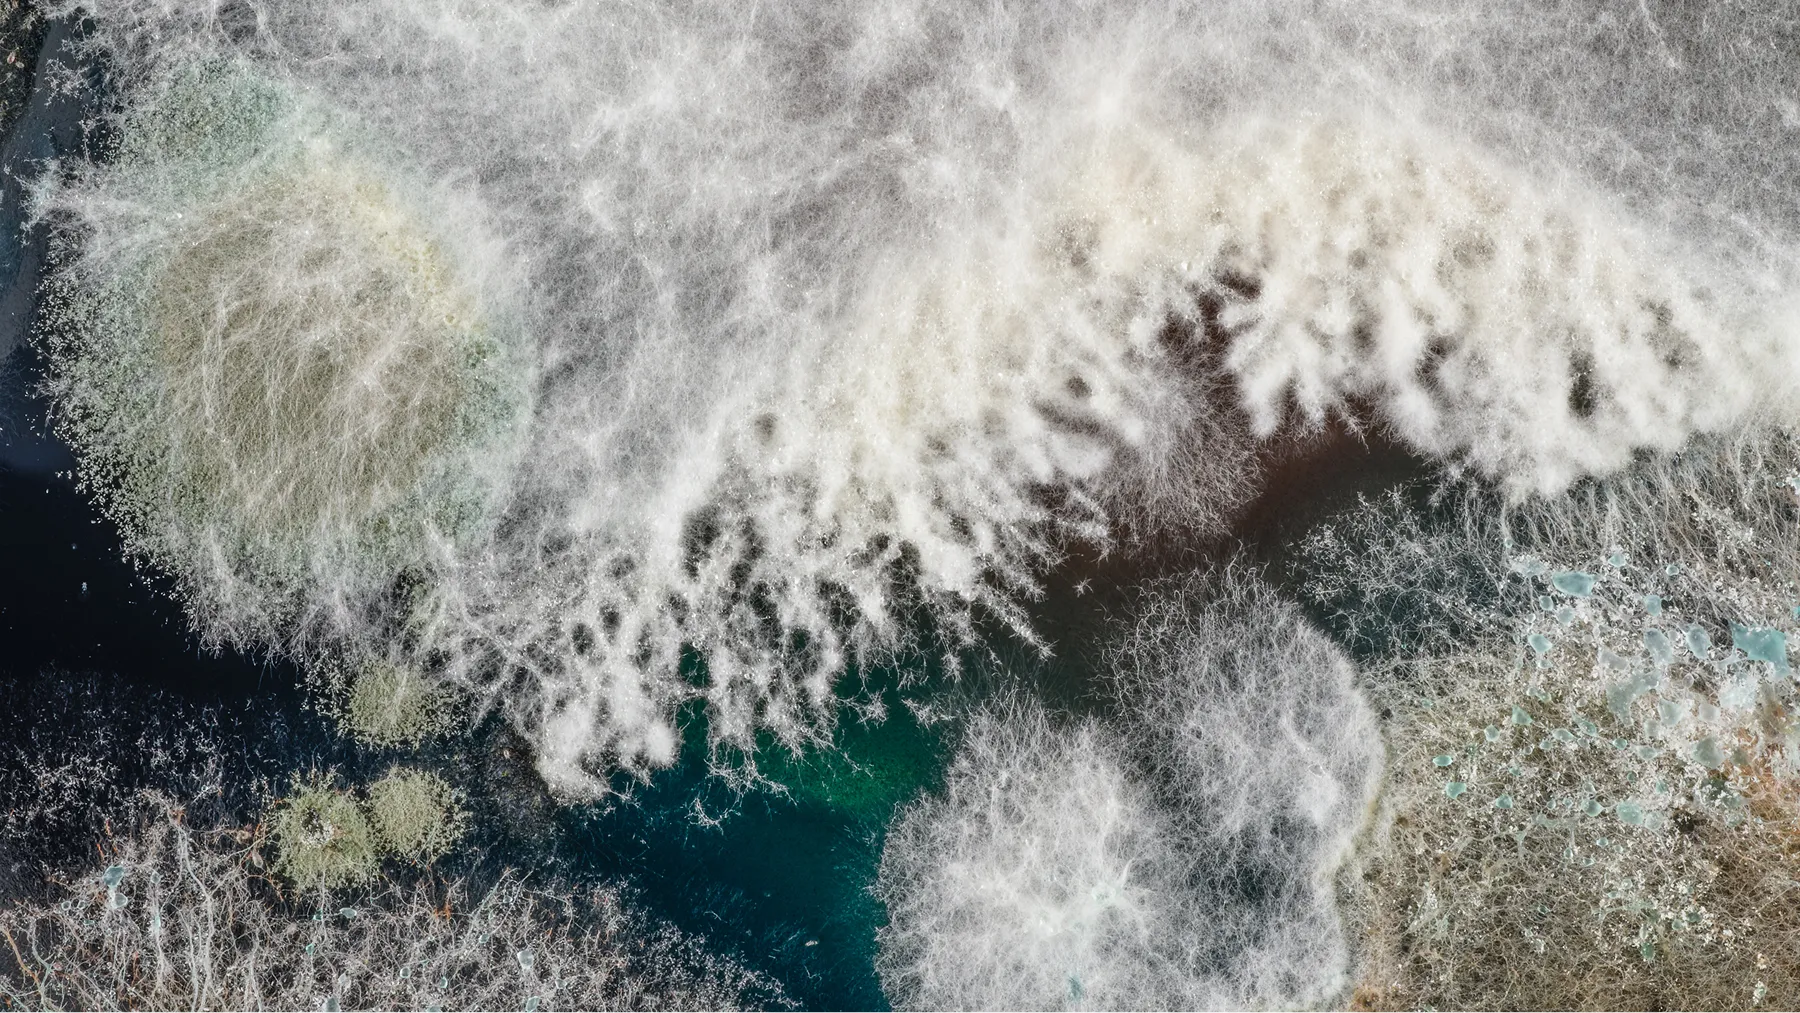
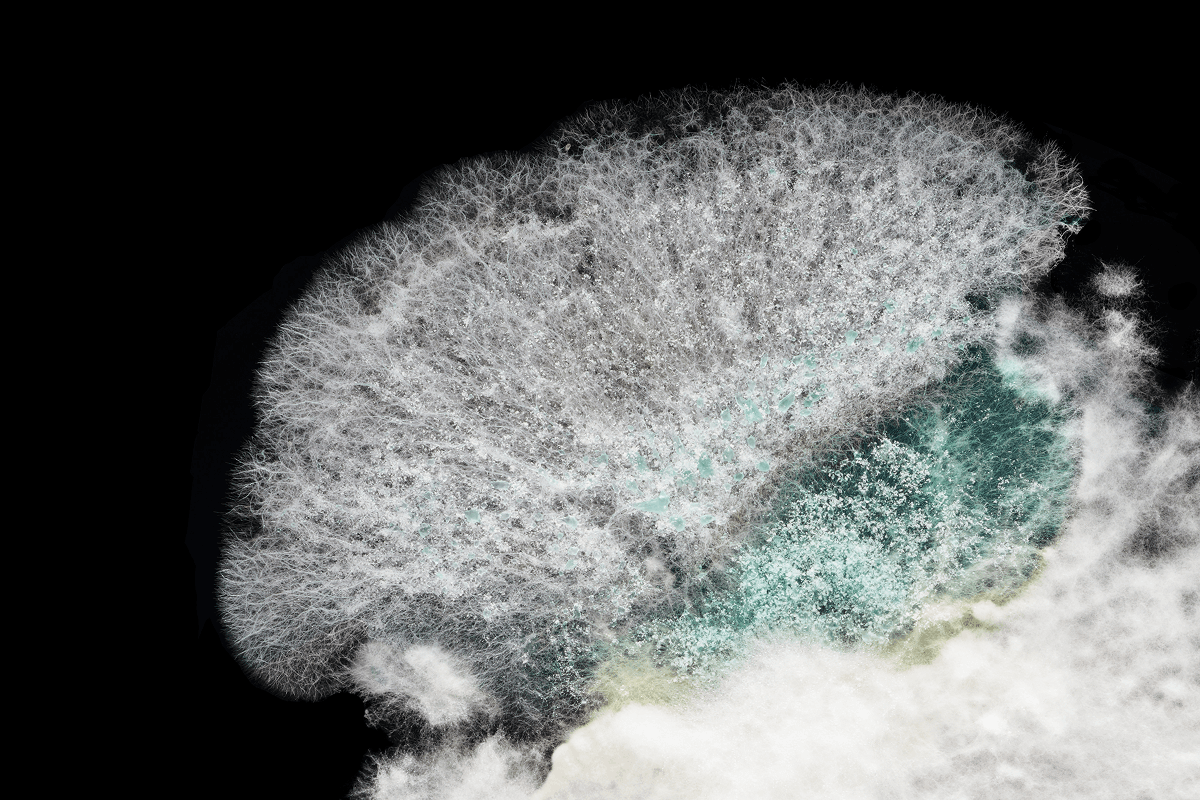

Mycelia and Mushrooms
Mycelia and mushrooms are powerful symbols of connection across cultures, bridging the seen and unseen, the physical and spiritual. For centuries, they have been used to access higher realms and deeper truths.
For her evolving video project—originally commissioned and presented by the conservationist performance group Vildwerk for the ballet Network (composed by David K. Israel and choreographed by Gianna Reisen) —Samantha turns her lens towards the mesmerizing world of fungi. For several months she lived closely with mushrooms, observing their rhythms, and learning about their cycles of light to dark, from decomposition to renewal.
By cultivating mycelia in petri dishes and using macro photography, Samantha reveals the hidden architecture of the mycelial network—delicate, intelligent threads beneath our feet that link forests, plants, and ecosystems. She also films mushrooms ejecting spores; a single one can release billions daily, traveling vast distances on air currents. We inhale them with every breath. In the end, mushrooms—and the vast, invisible networks they form—remind us that all life is woven into one interdependent web.

























.jpg)
.webp)
.webp)
.webp)
.webp)
.webp)
.webp)

.webp)


.webp)

.webp)

.webp)
.webp)

.webp)

.webp)
.webp)
.webp)

.webp)
.webp)
.jpg)




















.jpg)


.jpg)

.jpg)
.webp)
.webp)
.webp)
.webp)
.webp)
.webp)

.webp)


.webp)

.webp)

.webp)
.webp)

.webp)

.webp)
.webp)
.webp)

.webp)
.webp)

.jpg)
.webp)
.webp)
.webp)
.webp)
.webp)
.webp)
.webp)
.webp)
.webp)

.webp)
.webp)
.webp)
.webp)
.webp)
.webp)
.webp)
.webp)
.webp)
.webp)
.webp)
.webp)
.webp)
.webp)
.webp)
.webp)

























.jpg)

.webp)
.webp)
.webp)
.webp)
.webp)
.webp)

.webp)


.webp)

.webp)

.webp)
.webp)

.webp)

.webp)
.webp)
.webp)

.webp)
.webp)
.jpg)


























.webp)
.webp)
.webp)
.webp)
.webp)
.webp)

.webp)


.webp)

.webp)

.webp)
.webp)

.webp)

.webp)
.webp)
.webp)

.webp)
.webp)
.jpg)

























.jpg)




















.jpg)


.jpg)

.jpg)
“Music and dancing pull me into a space where I feel present, alive, and returned to my essential self—whether alone or part of a shared human experience. I feel the pulse of the earth, the rhythm that connects us and transcends the physical world, inviting the question of what we are connected to that remains unseen—something larger than ourselves that we sense, imagine, or intuit, but can’t fully name.
In a similar way, video and photography can illuminate the hidden patterns that shape our world. They open another window into the mysteries of our universe— disrupting our standard perspective and, in so doing, offering a glimpse into where we came from, who we are, and the vast, interconnected story we belong to.”
— Samantha Bass




















































.webp)
.webp)
.webp)
.webp)
.webp)
.webp)

.webp)


.webp)

.webp)

.webp)
.webp)

.webp)

.webp)
.webp)
.webp)

.webp)
.webp)
.jpg)

